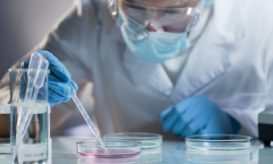

Καρκίνος του εγκεφάλου: Συνδυασμένη θεραπεία με λέιζερ αυξάνει σημαντικά την επιβίωση των ασθενών
Ένας στους τρεις πάσχοντες από επιθετικό αστροκύττωμα που είχε υποτροπιάσει, έζησαν 3 χρόνια.

Ένας στους τρεις πάσχοντες από επιθετικό αστροκύττωμα που είχε υποτροπιάσει, έζησαν 3 χρόνια.

Οι γιατροί της έδιναν 12-18 μήνες ζωής τον Φεβρουάριο του 2022 που διαγνώσθηκε. Εκείνη ξεπέρασε τα 3,5 χρόνια.

Ανησυχητικά ευρήματα νέας μελέτης σε χιλιάδες εθελοντές. Ποιοι κινδυνεύουν περισσότερο.

Η θεραπεία είναι πειραματική (ερευνητική). Δοκιμάζεται στη Βρετανία σε ασθενείς με υποτροπιάζον γλοιοβλάστωμα.

Τι έδειξε η δοκιμή του στον πρώτο μικρό ασθενή. Συγκρατημένοι αισιόδοξοι οι ερευνητές.

Το φάρμακο προορίζεται για εφήβους και ενήλικες με ορισμένα γλοιώματα. Τι λένε οι γιατροί που το μελέτησαν.

Ο καρκινικός όγκος του μικρού εξαφανίστηκε όταν πήρε ένα αντινεοπλασματικό φάρμακο στο πλαίσιο μελέτης.

Η απλή εξέταση ανιχνεύει με ακρίβεια που υπερβαίνει το 95% τις πιο συχνές μορφές της νόσου.
Τι ανακάλυψαν επιστήμονες από την Κρήτη μελετώντας την ανάπτυξη καρκίνου από λίγα κύτταρα σε πλήρη όγκο.

Το κοριτσάκι φέρει όγκο με μία σπάνια μετάλλαξη. Οι γιατροί του δεν μπόρεσαν να βρουν άλλο περιστατικό στην Ευρώπη.

Τι είναι ο ανοσοφθορισμός και πως μπορεί να βοηθήσει τους ασθενείς με κακοήθεις όγκους του εγκεφάλου. Πόσο βελτιώνει την...

Η συνεχής έκθεση στο τοξόπλασμα μπορεί να αυξάνει σημαντικά τις πιθανότητες να αναπτυχθεί καρκίνος του εγκεφάλου, σύμφωνα με μία...

Η καθημερινή έκθεση στους ρύπους των οχημάτων αυξάνει τον κίνδυνο αναπτύξεως καρκίνου του εγκεφάλου, αναφέρουν επιστήμονες από τον Καναδά.

Ο καρκίνος του εγκεφάλου προκαλεί δεκάδες θανάτους ετησίως στη χώρα μας, κυρίως σε ανθρώπους ηλικίας άνω των 50 ετών.